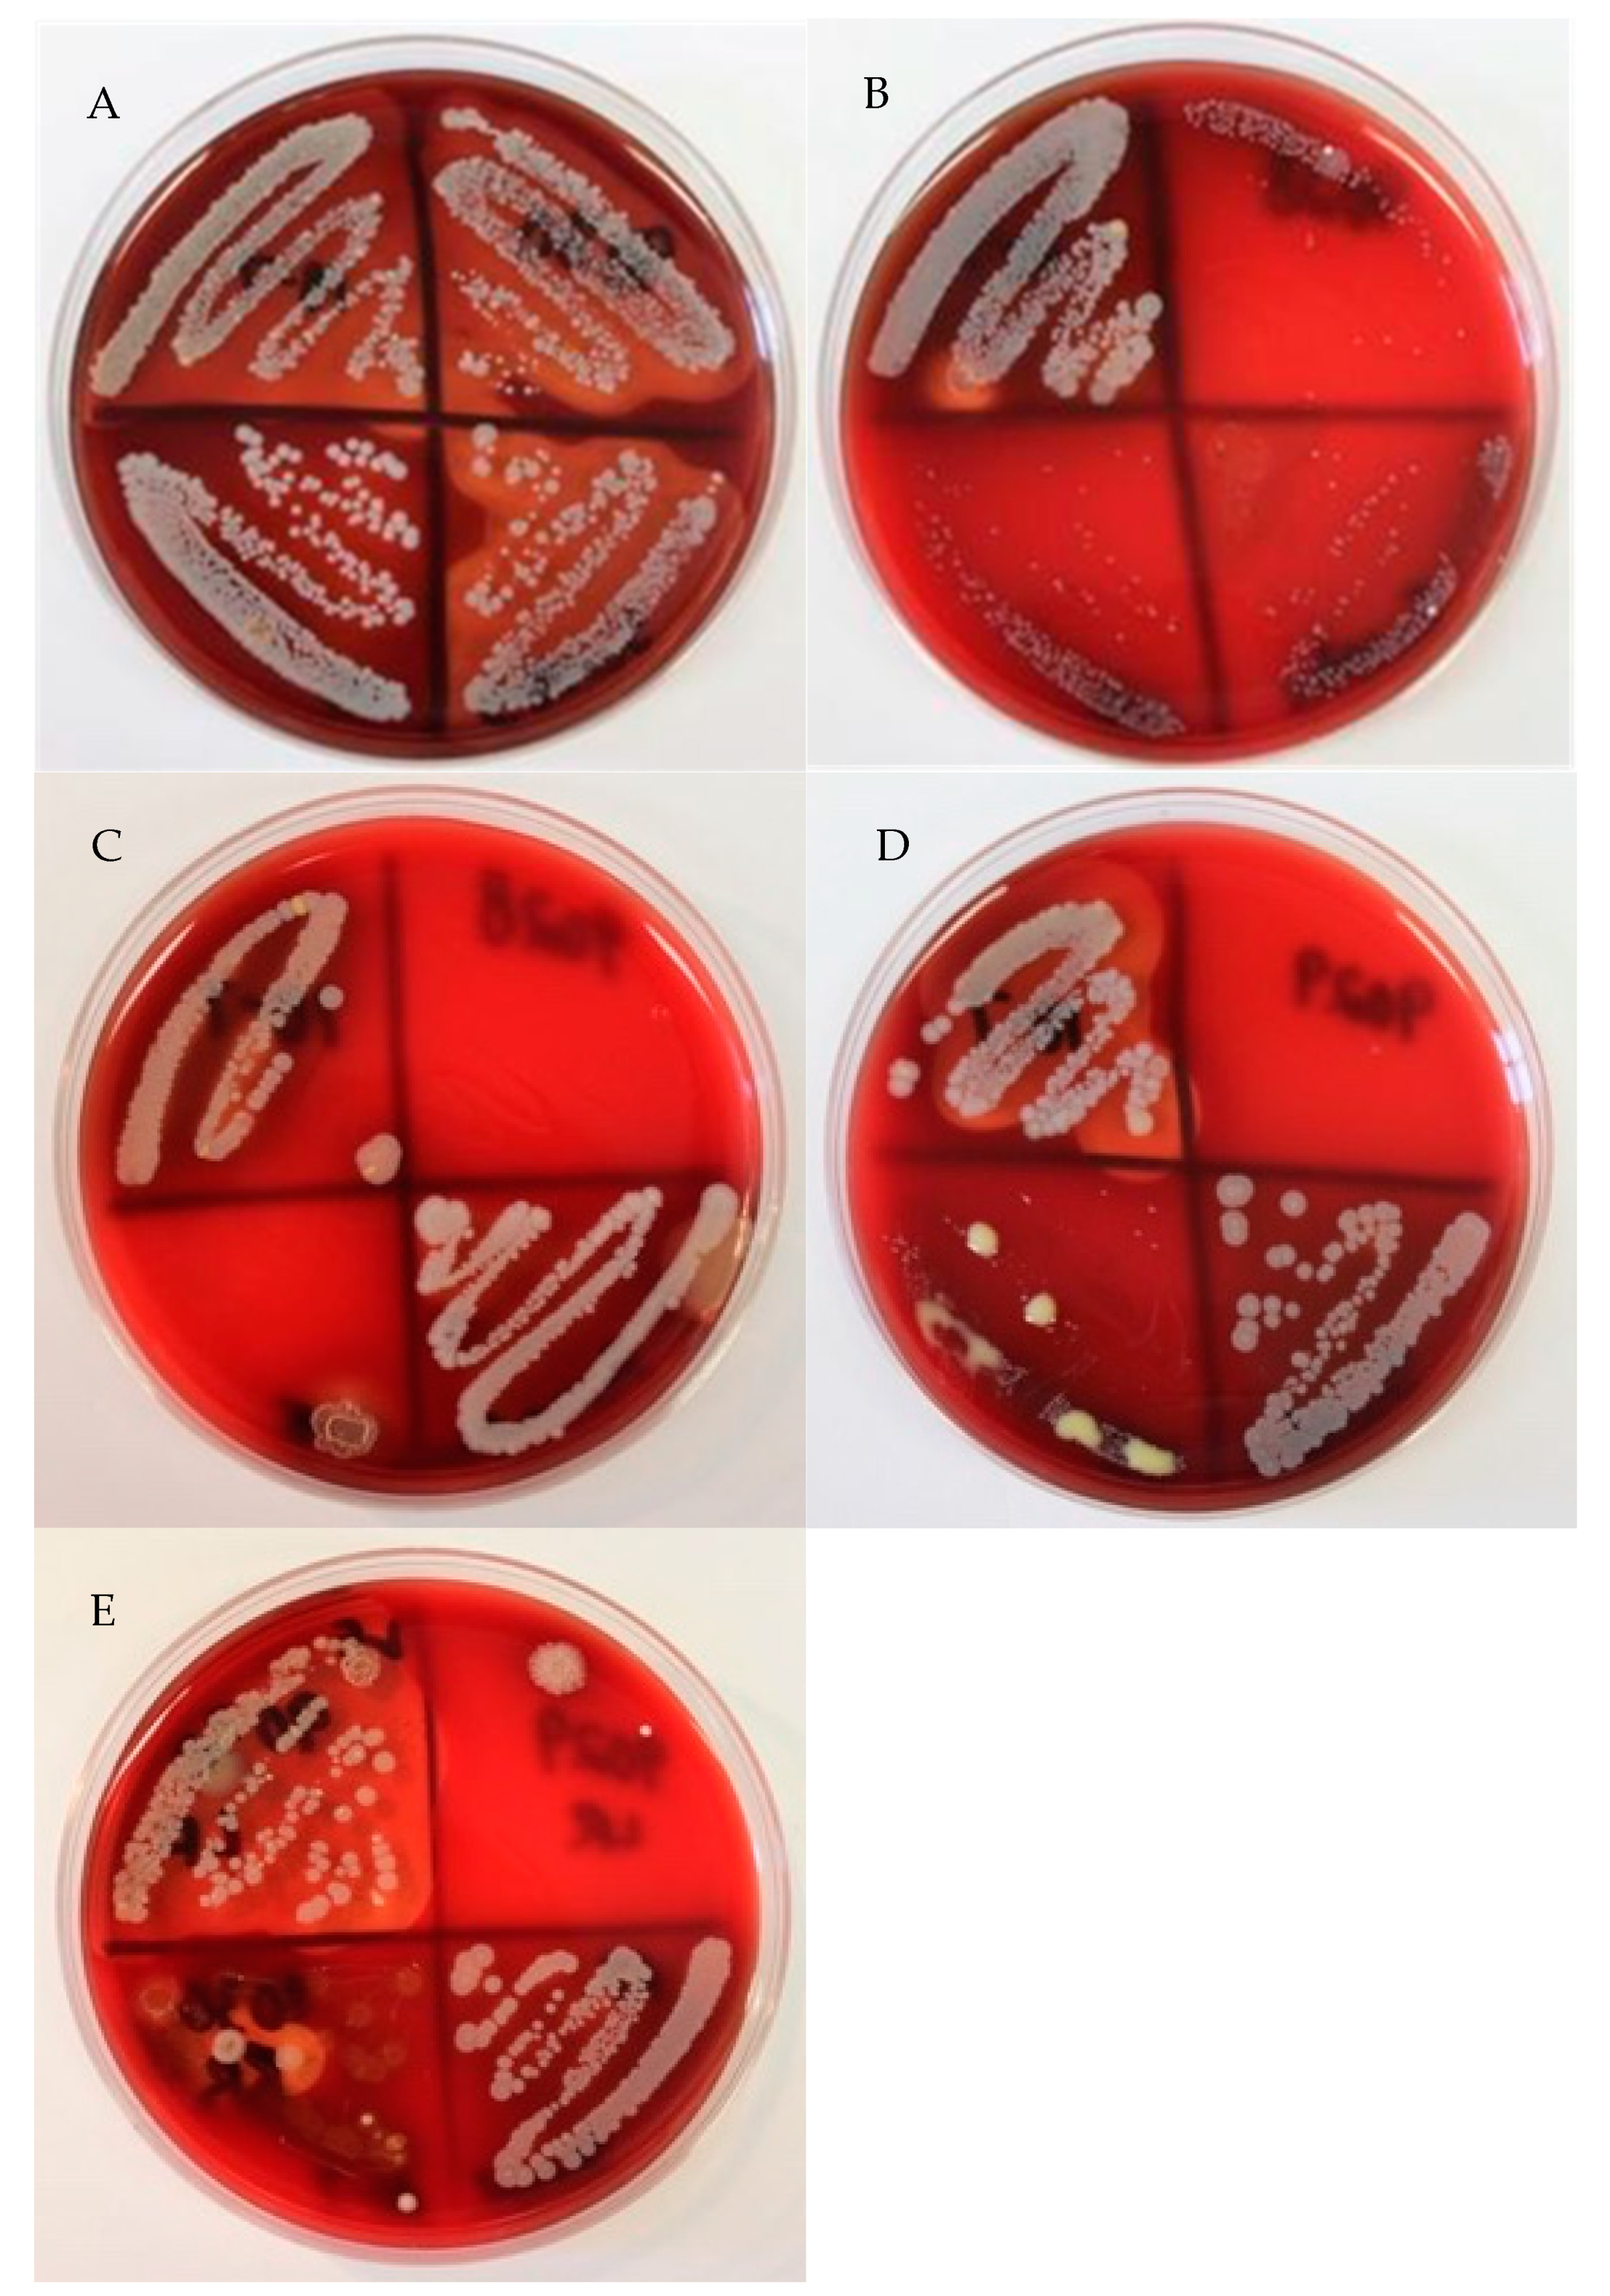
Animals 11 00252 g002

1. Introduction
Staphylococcus aureus continues to be a major cause of bovine mastitis. Managing this form of mastitis via preventative measures has been shown to be economically advantageous [
1,
2]. In addition, treatment of
S. aureus mastitis during lactation is economically justified in many situations [
3]. If therapy is delayed, the duration of infection increases and is accompanied by extended periods of bacterial shedding, elevated somatic cell counts (SCCs), scar tissue formation, and spread of infection to multiple quarters within a cow, all of which are associated with low cure rates [
4,
5] and transmission to other cows in the herd [
6].
Presumptive identification of
S. aureus on blood agar is largely based on observation of colony morphology, color, and hemolysis, typically both complete and incomplete. Because fewer than 5% of isolates express no hemolysis, it is widely accepted that the presence of complete and/or incomplete provides a strong diagnosis of
S. aureus, where lack of hemolysis indicates a non-aureus staphylococci (NAS). The NAS are typically distinguished from
S. aureus as being coagulase-negative staphylococci (CNS). A coagulase test, however, will not differentiate
S. aureus from the coagulase-positive species
Staphylococcus intermedius or the coagulase-variable species
Staphylococcus hyicus in the absence of hemolysis. Thus, an additional step commonly taken is to plate isolates on mannitol salt agar (MSA) to determine the capability of the isolate to ferment mannitol (
S. aureus is capable, whereas most NAS, including CNS, are not). Utilizing the MSA test in combination with the tube coagulase test enhances the specificity and sensitivity of identification [
7].
In past work assessing mastitis prevalence in Georgia dairies, it was noted that isolates presumptively identified as CNS were associated with the high SCCs typically observed with S. aureus, e.g., >500,000 cells/mL. Because of the elevated SCCs, further testing was carried out, which revealed these isolates were coagulase positive as well as MSA positive, indicating presumptive identification as S. aureus, rather than CNS, which prompted continued collection and testing of isolates. The purpose of this investigation was to determine the prevalence of these non-hemolytic S. aureus isolates that were misclassified as CNS. The correct identification is important from a mastitis management standpoint, as all cows diagnosed with S. aureus mastitis should be managed much differently than those with CNS mastitis, such as separating from the lactating herd to prevent contagious spread of S. aureus.
2. Materials and Methods
A total of 222 mammary secretions had been previously aseptically collected from bred Holstein heifers and lactating cows. Bred Holstein heifers and lactating cows were housed and cared for in the University of Georgia Teaching Dairy [
8]. The average herd size across the 10 years of data collection was approximately 111 lactating cows housed in a conventional freestall barn with an average milk yield of 66.1 lbs/cow and an average somatic cell count (SCC) of 273,500 cells/mL. Lactating dairy animals were milked 2 times/day in a double-6 herringbone parlor. After collection, mammary secretions were plated on trypticase soy agar plates with 5% sheep blood using an aseptic technique. Plates were incubated for 48 h at 37 °C and then visually inspected for the presence of colony growth. Through presumptive identification based on colony color, morphology, and presence of hemolysis (discussed in the succeeding paragraph), a determination was made regarding whether isolates were
S. aureus or other staphylococci (such as CNS).
Colonies that were creamy to grayish-white or yellow, smooth, circular, catalase positive, and that exhibited a narrow zone of complete hemolysis and a wide zone of incomplete hemolysis, were identified as S. aureus. Colonies identified as CNS because no hemolysis was present were further tested with the tube coagulase test and the MSA test. The tube coagulase test was performed according to basic microbiological procedures. To perform the MSA test, an MSA plate streaked with bacteria was incubated for 24 h at 37 °C. The MSA test was deemed positive if the bacteria colonized the agar surface and the plate medium turned bright yellow, indicating that the pathogen was able to grow in a high saline environment and fermented mannitol to produce the color change. If the bacteria colonized the agar surface, but the medium did not change color (remained pink), the test was deemed negative (for mannitol fermentation).
A coagulase-positive, MSA-positive result was categorized as S. aureus given its growth requirements and characteristics, despite the lack of hemolysis. A coagulase-negative, MSA-negative isolate was termed a CNS. A coagulase-positive, MSA-negative isolate was termed a coagulase-positive staphylococci (CPS). We also tested a subset of the nonhemolytic S. aureus isolates (approximately 60%) using the API®Staph system (bioMerieux, Inc., Marcy l’Etoile, France) according to manufacturer’s specifications to further support our S. aureus identification. All isolates tested were determined to be S. aureus. The API®Staph system was also used to test a selection of the CNS and CPS isolates to determine various species of staphylococci detected from cases of mastitis.
The distribution of infections amongst the quarters was described and analyzed by the non-parametric Kruskal–Wallis test with Dunn’s post-hoc testing.
3. Results and Discussion
After plating and testing 222 mammary secretions, the data showed that 63.96% (142 out of 222) of the isolates presumed to be CNS isolates were identified as
S. aureus (
Figure 1). Additionally, 8.56% (19 out of 222) of the isolates presumed to be CNS isolates were identified as CPS species. A total of 27.48%, (61 out 222) of the samples that were presumed to be CNS isolates were identified correctly. In the current study, not all nonhemolytic
S. aureus colonies were consistent in appearance, but many of them were grayish-white without areas of hemolysis surrounding the colonies (
Figure 2). The agar displayed a green hue (alpha hemolysis) behind and around the colonies. The centers of many atypical
S. aureus isolates were raised and exhibited a slightly different color than the rest of the colony.
According to the Laboratory Handbook on Bovine Mastitis [
9],
S. aureus isolates are presumptively identified as follows: Isolates are Gram-positive as well as catalase-positive cocci. Culturing of these isolates reveals creamy, grayish-white to golden-yellow colonies with distinct areas of incomplete hemolysis, with or without areas of narrow complete hemolysis. However, as reported in this study, the
S. aureus isolates identified were not hemolytic, resulting in incorrect presumptive identification as CNS isolates. Although it is noted in the Laboratory Handbook on Bovine Mastitis that not all isolates will demonstrate hemolysis, the presence of hemolysis for
S. aureus identification is still a commonly held belief, especially in on-farm milk culturing.
Typical CNS isolates are nonpigmented, creamy grayish-white, tan, or golden-yellow colonies. These isolates do not display complete hemolysis typical of
S. aureus; however, some species of CNS have been reported to display diffuse zones of hemolysis. Thus, isolates lacking the typical hemolytic patterns are presumptively identified as CNS species. As stated in the Materials and Methods, a selection of isolates was tested utilizing the API
®Staph system. The genus and species identification of those that were not
S. aureus are shown in
Figure 3. An incorrect diagnosis could directly impact managerial decisions for cow management. Depending on the mastitis prevention and control plan for an operation, cows diagnosed with
S. aureus may be considered for extended intramammary antibiotic therapy, alternative intramammary antibiotics, separation from herd mates, and altered milking order to prevent spread, reevaluation of fly control methods, and culling [
10].
Given the concerns surrounding
S. aureus and its impact on mammary health and milk production, we were also interested in determining whether a relationship existed between these nonhemolytic
S. aureus isolates and afflicted quarters of the dairy animal. Previous research found a relationship between
S. aureus infection and the quarter affected, where front teats were more likely to be infected with
S. aureus compared to rear teats [
11]. Therefore, we investigated this potential dynamic in the current study. In quarters infected with nonhemolytic
S. aureus, 32.39% of the isolates were collected from the right front (RF) quarters, 23.24% from the left front (LF) quarters, 17.61% from the left rear (LR) quarters, and 26.76% from the right rear (RR) quarters (
Figure 4). The left quarters displayed fewer nonhemolytic infections numerically; however, only the LR statistically differed from the RF and RR, with fewer identified
S. aureus infections (
p < 0.05). In quarters infected with CNS, 26.23% of the isolates were collected from the RF quarters, 22.95% from the LF quarters, 31.15% from the LR quarters, and 19.67% from the RR quarters. In contrast to the
S. aureus infections, the LR CNS cases were significantly greater than the RR ones (
p < 0.05), but not different from the RF or LF ones. Lastly, in quarters infected with CPS, 36.84% of the isolates were collected from the RF quarters, 31.58% from the LF quarters, 21.05% from the LR quarters, and 10.53% from the RR quarters. The RF CPS cases were significantly greater than the RR cases.
We expected to see a greater percentage of
S. aureus infections in the front quarters, as was observed in previous research. The front quarters/teats are in close proximity to the umbilical region of the animal, which is where fly populations tend to be greatest. Horn flies have been identified as important vectors in the spread of
S. aureus, especially in heifers [
12]. Though the RF quarters did represent a greater percentage compared to the LR, the RF was also greater than the LF, a result that is not fully understood. Additional isolates of CPS species would be needed to fully evaluate the quarter-level relationships identified in the current study, especially given the significant difference between the LR and RR. There is not a clear biological reason why prevalence of infection would be different in the left side versus the right side of the dairy animal. Behavioral investigations (animal and human) could reveal animals that prefer to lay on one side, and thus put one side of their mammary gland at risk over the other, or perhaps these animals prefer to enter the milking parlor on the same side each time, which happens to be the farthest away from the milker, and that far side is less thoroughly cleaned as is anecdotally observed during farm visits and milker trainings. However, this is conflicting when you compare the rear quarters of
S. aureus with the rear quarters of CNS. Why does this happen? Ultimately, it is unclear why these differential associations exist between quarters and pathogens; nonetheless, the results are important to report. Interpretation of the results is limited given the combination of heifer secretions and milk samples, as well as the combination of subclinical and clinical cases; thus, the quarter-level differences require further investigation.
An important note for the current study is that the isolates were collected from one Georgia farm. It is possible, and quite likely, that the extremely high rate of nonhemolytic S. aureus isolates was specific to this farm and the circulating strains on that unit. However, many dairy operations that do not actively culture and/or are just new to implementing a culturing program, especially on-farm, may not know the microbiological make-up of their mastitis-causing pathogen profile. This report serves as a word of caution, and perhaps suggestion that further simple microbiological tests are performed to increase confidence in diagnosis. On-farm milk culturing is a low-cost, valuable tool in mastitis control plans; thus, future studies should focus on performing collections and microbiological analysis on various farms throughout the region to determine the potential depth and breadth of this issue.
When possible, consideration should be taken to conduct identification using gold standard techniques that surpass basic microbiological techniques. For example, DNA and protein technology enable rapid, accurate diagnosis of common mastitis-causing pathogens, such as
S. aureus and many CNS/CPS [
13]. Moreover, these technologies allow for differentiation between CNS and CPS species as well. As we learn more about the immune responses of bacteria and their response to various treatment plans, it may become important to not only differentiate between
S. aureus and CNS/CPS, but also
S. hyicus vs.
S. chromogenes, as an example. This is already the case for environmental streptococci such as
Streptococcus uberis and
S. dysgalactiae. More than 5 years ago, DNA-based techniques rose in popularity and are still used in many labs today. DNA-based technology provides improved accuracy over microbiological culturing and biochemical assays in a shorter period of time. Several companies currently market on-farm PCR systems to identify a few of the most predominant mastitis pathogens, though implementation of these on-farm systems are cost-prohibitive for many operations. While DNA-based technologies are superior to culturing and simple biochemical assays, there are still limitations in that only the most common bacteria are capable of being identified (currently) and both live and dead bacteria are detected, which could complicate real-time antibiotic therapy strategies [
13]. In light of these limitations, matrix-assisted laser desorption/ionization time-of-flight mass spectrometry (MALDI-TOF MS) has become the preferable choice for rapid, accurate diagnosis because of the comparative databases for identification [
14]. While there are still considerations for the challenges of MALDI-TOF (i.e., the sample must be a pure culture, free from contaminating pathogens), this limitation does not preclude its value moving forward in identification of mastitis-causing bacteria, as subcultures of causative pathogens following visual assessment can be garnered.